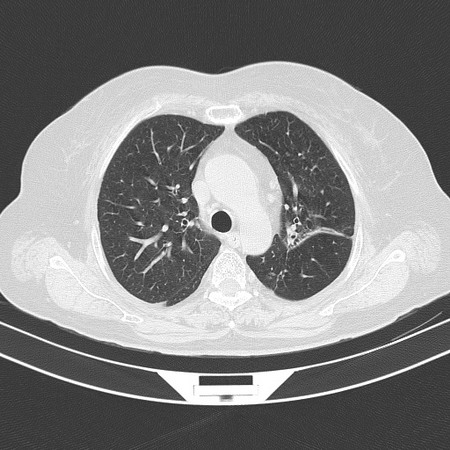
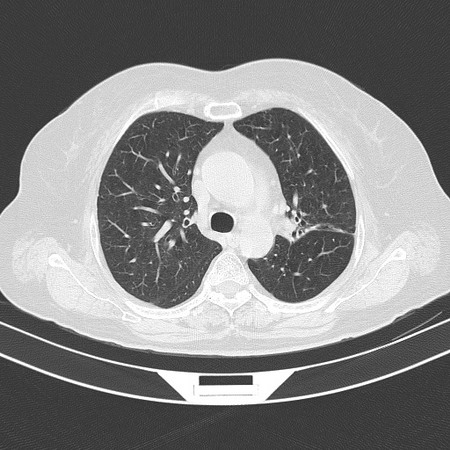

以下是引用sdzyy在2008-11-21 14:57:00的发言:[br]右肺结节影,建议定期复查!支扩,左侧叶间胸膜增厚.
以下是引用sdzyy在2008-11-21 14:57:00的发言:[br]右肺结节影,建议定期复查!支扩,左侧叶间胸膜增厚.
以下是引用卜一在2008-11-21 14:40:00的发言:[br]炎性结节可能!建议定期复查!另:支气管扩张征伴感染!
以下是引用guanaishengming在2008-11-21 17:26:00的发言:[br]右肺结节影,建议定期复查!
以下是引用卜一在2008-11-21 14:40:00的发言:[br]炎性结节可能!建议定期复查!另:支气管扩张征伴感染!
| 欢迎光临 医影在线 (http://bbs.radida.com/bbs/) | Powered by Discuz! X3.2 |